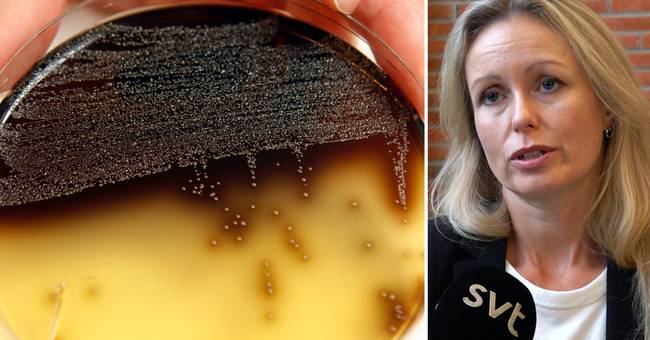

Questi sono tre diversi casi di infezione da listeriosi senza un collegamento provato tra loro.
– Quando intervistiamo i parenti di questi casi, non vediamo alcun filo conduttore, dice Skogstam a SVT Nyheter Värmland.
Nei comuni in cui è presente il batterio Listeria, vengono effettuati test e gli alimenti sospettati di trasportare i batteri vengono inviati alla National Food Administration.
Listeria trovata nel prodotto commestibile
La National Food Administration, che sta conducendo l’indagine, ha trovato batteri di listeria in un prodotto commestibile presso un produttore alimentare a Värmland. NWT Primo a denunciare. L’autorità ha deciso di vietare di portare cibo da lì al mercato.
– Si applica immediatamente e fino a nuovo avviso. Quando le deviazioni che stanno alla base del divieto vengono affrontate, possono essere revocate, afferma Peter Johnson, capo della supervisione dell’azienda alimentare presso la National Food Administration di SVT.
Indica anche che non sanno ancora se è stato lo stesso ceppo di Listeria a causare i decessi.
– Non ci sono ancora analisi che mostrino di quale tribù si tratta.
si trova nel cibo
Listeria può verificarsi in alimenti come salumi, salmone in salamoia e formaggio non pastorizzato. Ma la dottoressa per il controllo delle infezioni Anna Skogstam sottolinea che la listeria generalmente non è qualcosa di cui dovresti aver paura.
La maggior parte delle persone può mangiare questi cibi senza ammalarsi, quindi quando appartieni a gruppi ad alto rischio dovresti evitarli.
I gruppi a rischio includono quelli con un sistema immunitario indebolito, gli anziani e le donne in gravidanza.

“Evangelista della musica. Fanatico del cibo malvagio. Ninja del web. Fan professionista dei social media. Maniaco dei viaggi sottilmente affascinante.”

More Stories
Il numero di persone con allergie ai pollini è aumentato del 25%.
Siate felici! Approvazione di un nuovo vaccino contro il colera – Global Bar Magazine
Il nostro appello ai medici riguardo a Ozempic è coerente